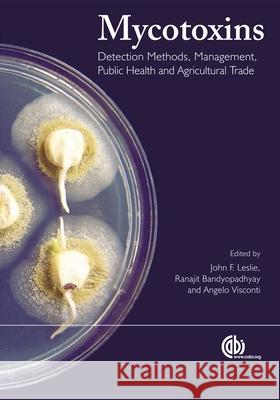
Mycotoxins: Detection Methods, Management, Public Health and Agricultural Trade J. Leslie R. Bandyopadhyay A. Visconti 9781845930820 CABI Publishing

» książki » Medical - Toxicology
|
Mycotoxins: Detection Methods, Management, Public Health and Agricultural Trade
ISBN: 9781845930820 / Angielski / Twarda / 480 str. Termin realizacji zamówienia: ok. 5-8 dni roboczych. Mycotoxins are produced worldwide by several fungi on a wide range of agricultural commodities and are closely related to human and animal food chains. Examining mycotoxins and their impact from a public health viewpoint, this book provides an overview and introduction to the subject and examines the health, trade and legislation issues involved. Management of mycotoxins is discussed in detail as well as the global problems caused by mycotoxins.
Mycotoxins are produced worldwide by several fungi on a wide range of agricultural commodities and are closely related to human and animal food chains...
|
cena:
748,36 |
 |
Molecular Toxicology
ISBN: 9781859963456 / Angielski / Miękka / 164 str. Termin realizacji zamówienia: ok. 5-8 dni roboczych. Molecular Toxicology is a concise introduction to the subject, taking the reader through the theoretical principles of toxicology followed by specific examples. In the first section, the concepts behind possible mechanisms of toxicity are described (e.g. the specific enzyme or receptor system) using examples where appropriate. Following this a series of examples are used to show the extension of concept into the real world, in an organ specific manner. The book concludes with a section outlining toxicity assessment methods, where the impact of molecular biology is having a considerable...
Molecular Toxicology is a concise introduction to the subject, taking the reader through the theoretical principles of toxicology followed by specific...
|
cena:
349,00 |
 |
Toxins and Signal Transduction
ISBN: 9789057020780 / Angielski / Twarda / 518 str. Termin realizacji zamówienia: ok. 5-8 dni roboczych. Of the multitude of toxins known and the enormous variety of effects they cause, of particular interest are those that influence signal transduction. Intercellular communication by chemical signals is essential for the functioning of multicellular organisms. Many toxins exert their biological effects by interfering with the signal transduction initiated by these chemicals (hormones, transmitters, growth factors, and other mediators). Up-to-date information is provided by outstanding experts, who discuss the molecular mechanisms involved in the action of many toxins, as well as the use of...
Of the multitude of toxins known and the enormous variety of effects they cause, of particular interest are those that influence signal transduction. ...
|
cena:
1211,96 |
 |
Mistletoe: The Genus Viscum
ISBN: 9789058230928 / Angielski / Twarda / 274 str. Termin realizacji zamówienia: ok. 5-8 dni roboczych. This book provides a comprehensive overview of current knowledge in mistletoe use from well recognised researchers and is an invaluable reference source for anyone with interest in the applications of this plant.
This book provides a comprehensive overview of current knowledge in mistletoe use from well recognised researchers and is an invaluable reference sour...
|
cena:
751,42 |
 |
Exposure to Contaminants in Drinking Water: Estimating Uptake through the Skin and by Inhalation
ISBN: 9780849328046 / Angielski / Twarda / 272 str. Termin realizacji zamówienia: ok. 5-8 dni roboczych. Exposure to Contaminants in Drinking Water: Estimating Uptake through the Skin and by Inhalation examines the current state of science in th is field by identifying and reviewing the available information resour ces; evaluating various models and approaches; and demonstrating the f easibility of developing estimates of the distribution of absorbed dos es of contaminants in drinking water through contact with the skin and by inhalation. This book, the product of a fifteen-member expert work ing group convened by the Risk Science Institute of the International Life Sciences Institute under a...
Exposure to Contaminants in Drinking Water: Estimating Uptake through the Skin and by Inhalation examines the current state of science in th is field ...
|
cena:
775,66 |
 |
Target Organ Toxicity, Volume I
ISBN: 9780849357756 / Angielski / Twarda / 240 str. Termin realizacji zamówienia: ok. 5-8 dni roboczych. This two-volume set provides essential information on the general princi-ples of target organ toxicity. Pharmacokinetics, metabolic activation and key defense mechanisms, excretion, species variation, and tissue-specific biochemistry are explored comprehensively. These general principles are then illustrated using specific examples of toxicity to different target organs and systems. DNA modifi-cation and repair in tumor induction, and specificity in tumor initiation are also examined. Of primary interest to toxicologist, pharma-cologists, biochemists, and environmental toxicologists.
This two-volume set provides essential information on the general princi-ples of target organ toxicity. Pharmacokinetics, metabolic activation and key...
|
cena:
1454,36 |
 |
Xenobiotic Metabolism and Disposition: The Design of Studies on Novel Compounds
ISBN: 9780849361630 / Angielski / Twarda / 232 str. Termin realizacji zamówienia: ok. 5-8 dni roboczych. This publication explains the principles of the techniques used in disposition and metabolism studies in animals, in man, and in vitro. It includes methods for studying routes and rates of absorption, distribution, metabolism, and excretion of novel compounds and their metabolites. Relevant surgical, whole-body autoradiographic and pharmacokinetic procedures are discussed, together with techniques for separating and identifying metabolites and metabolic path-ways. Information on when the procedures are appropriate, and examples of what they represent, are presented in order to illustrate the...
This publication explains the principles of the techniques used in disposition and metabolism studies in animals, in man, and in vitro. It includes me...
|
cena:
1696,75 |
 |
Pvp: A Critical Review of the Kinetics and Toxicology of Polyvinylpyrrolidone (Povidone)
ISBN: 9780873712880 / Angielski / Twarda / 232 str. Termin realizacji zamówienia: ok. 5-8 dni roboczych. Polyvinylpyrrolidone (PVP) is widely used in medicine, pharmaceuticals, cosmetics, foods, printing inks, textiles, and many more diverse applications. This book describes the research on the absorption, distribution, storage, and excretion of PVP. It reviews the toxicological studies performed on PVP, including acute, subchronic, and mutagenicity.
Polyvinylpyrrolidone (PVP) is widely used in medicine, pharmaceuticals, cosmetics, foods, printing inks, textiles, and many more diverse applications....
|
cena:
2060,34 |
 |
Inhibition of Angiogenesis by Potential Chemopreventive Agents
ISBN: 9783639036305 / Angielski / Miękka / 132 str. Termin realizacji zamówienia: ok. 5-8 dni roboczych. A new human in vitro anti-angiogenesis assay was established and applied to identify novel angiopreventive agents. Subsequently, two chemopreventive compounds, xanthohumol (XN) from Humulus lupulus L. (hop) and sulforaphane (SFN), an isothiocyanate derived from cruciferous vegetables (Brassicaceae), were selected for detailed investigation of their angiopreventive potential and mechanisms involved in the inhibition of angiogenesis. Representative targets included effects at the transcriptional levels of pro-angiogenic factors, anti-gelatinolytic and anti-endothelial activity. In vivo, XN was...
A new human in vitro anti-angiogenesis assay was established and applied to identify novel angiopreventive agents. Subsequently, two chemopreventive c...
|
cena:
263,91 |
 |
Modelling of Environmental Chemical Exposure and Risk
ISBN: 9780792367758 / Angielski / Twarda / 275 str. Termin realizacji zamówienia: ok. 5-8 dni roboczych. Mathematical models are being increasingly used to estimate the concentrations of a wide range of substances in the environment for a variety of reasons, including government control and legislation, and risk and hazard estimation. Exposure assessment has to be performed for many types of substances, including pesticides, industrial chemicals, pollutants, accidental discharges, etc. The interpretation of the results of model equations should always bear in mind the purpose for which the model used was built in the first place. Further, models are always an abstraction of reality, requiring...
Mathematical models are being increasingly used to estimate the concentrations of a wide range of substances in the environment for a variety of reaso...
|
cena:
402,53 |
 |
Heart Rate Variability and Ultrafine Particle Exposures
ISBN: 9783639015447 / Angielski / Miękka / 240 str. Termin realizacji zamówienia: ok. 5-8 dni roboczych. |
cena:
364,22 |
 |
Fitoterapia i leki roślinne
ISBN: 9788320046502 / Polski / Miękka / 500 str. Termin realizacji zamówienia: ok. 5-8 dni roboczych. Autorzy zapoznają czytelników z nowoczesną fitoterapią, znaczeniem leku roślinnego w leczeniu wielu schorzeń. Część I zawiera charakterystykę chemiczną, biochemiczną i farmakologiczną podstawowych grup substancji roślinnych oraz surowców zielarskich stosowanych we współczesnej fitoterapii. W części II omówiono terapeutyczne zastosowanie surowców zielarskich, przetworów ziołowych oraz środków farmaceutycznych (leków ziołowych). Uwzględniono ich działanie farmakologiczne, trwałość, kierunek rozpadu i jego konsekwencje, interakcje, toksyczność. Szczegółowo...
Autorzy zapoznają czytelników z nowoczesną fitoterapią, znaczeniem leku roślinnego w leczeniu wielu schorzeń. Część I zawiera charakterystyk�...
|
cena:
194,01 |
 |
Materials Issues in a Hydrogen Economy - Proceedings of the International Symposium
ISBN: 9789812838018 / Angielski / Twarda / 376 str. Termin realizacji zamówienia: ok. 5-8 dni roboczych. This proceedings of the International Symposium on Materials Issues in a Hydrogen Economy addresses fundamental materials science issues and challenges concerning the production, storage, and use of hydrogen. The volume also deals with safety and education issues. The contributors researchers in physics, chemistry, materials science, and engineering share their ideas and results to delineate outstanding materials problems in a hydrogen economy and to guide the future research.
This proceedings of the International Symposium on Materials Issues in a Hydrogen Economy addresses fundamental materials science issues and challenge...
|
cena:
581,74 |
 |
Sulfur Analogues of Polycyclic Aromatic Hydrocarbons (Thiaarenes): Environmental Occurrence, Chemical and Biological Properties
ISBN: 9780521103565 / Angielski / Miękka / 296 str. Termin realizacji zamówienia: ok. 5-8 dni roboczych. First published in 1990. Sulfur containing polycyclic aromatic compounds (thiaarenes) play a potentially important role in environmentally induced cancers.
First published in 1990. Sulfur containing polycyclic aromatic compounds (thiaarenes) play a potentially important role in environmentally induced can...
|
cena:
253,95 |
 |
Calomel in America: Mercurial Panacea, War, Song and Ghosts
ISBN: 9781599424675 / Angielski / Miękka / 236 str. Termin realizacji zamówienia: ok. 5-8 dni roboczych. Formed as a word and a chemical compound in an culturally diverse Europe, calomel came to America as a solution to epidemics also imported. It grew into a primary gesture, both medical and commercial, of the healing professions. Opposition to its use, founded on experience with the effects of consuming it, took the form of song and satire that echoed faintly after the drug was forgotten.
Formed as a word and a chemical compound in an culturally diverse Europe, calomel came to America as a solution to epidemics also imported. It grew in...
|
cena:
131,54 |
 |
Modelling of Environmental Chemical Exposure and Risk
ISBN: 9780792367765 / Angielski / Miękka / 275 str. Termin realizacji zamówienia: ok. 5-8 dni roboczych. Mathematical models are being increasingly used to estimate the concentrations of a wide range of substances in the environment for a variety of reasons, including government control and legislation, and risk and hazard estimation. Exposure assessment has to be performed for many types of substances, including pesticides, industrial chemicals, pollutants, accidental discharges, etc. The interpretation of the results of model equations should always bear in mind the purpose for which the model used was built in the first place. Further, models are always an abstraction of reality, requiring...
Mathematical models are being increasingly used to estimate the concentrations of a wide range of substances in the environment for a variety of reaso...
|
cena:
402,53 |
 |
Illustrated Handbook of Toxicology
ISBN: 9783131269218 / Angielski / Miękka / 360 str. Termin realizacji zamówienia: ok. 5-8 dni roboczych. The Illustrated Handbook of Toxicology is an impressive introduction to the complex field of toxicology. It also serves as a hands-on guide to various poison treatments and offers supplemental public health information. Each two-page unit features concise text on the left complemented by full-color illustrations on the opposing page. The expert author distinguishes harmful toxic substances and catalogues their specific effects on the human body, plants, animals, and the surrounding environment. The handbook also addresses cutting-edge topics, including... The Illustrated Handbook of Toxicology is an impressive introduction to the complex field of toxicology. It also serves as ... |
cena:
386,69 |
 |
Dioxin Perspectives:: A Pilot Study on International Information Exchange on Dioxins and Related Compounds
ISBN: 9780306439162 / Angielski / Twarda / 772 str. Termin realizacji zamówienia: ok. 5-8 dni roboczych. Fifteen reports describe the findings and accomplishments of the NATO/CCMS Pilot Study on International Information Exchange on Dioxins and Related Compounds, which began May 1985, in Brussels, Belgium, and concluded April 1988, in Berlin, Germany. Working groups report on exposure and hazard assess
Fifteen reports describe the findings and accomplishments of the NATO/CCMS Pilot Study on International Information Exchange on Dioxins and Related Co...
|
cena:
407,16 |
 |
Endocrine Toxicology
ISBN: 9781420093094 / Angielski / Twarda / 424 str. Termin realizacji zamówienia: ok. 5-8 dni roboczych. Examines endocrine toxicology's increased importance in environmental safety issues due to legislative directives established over the past ten years. With contributions by international experts in academia, chemical manufacturing, government research laboratories, regulatory agencies, and private consulting, this guide explores the potentially damaging influence of environmental agents on the endocrine system. Examines endocrine toxicology's increased importance in environmental safety issues due to legislative directives established over the past ten yea... |
cena:
581,74 |
 |
In Vitro Methods in Toxicology
ISBN: 9780521104753 / Angielski / Miękka / 472 str. Termin realizacji zamówienia: ok. 5-8 dni roboczych. The volume brings together the once disparate knowledge of cultural techniques and thus provides an important reference work for industrial and academic toxicologists.
The volume brings together the once disparate knowledge of cultural techniques and thus provides an important reference work for industrial and academ...
|
cena:
303,89 |













